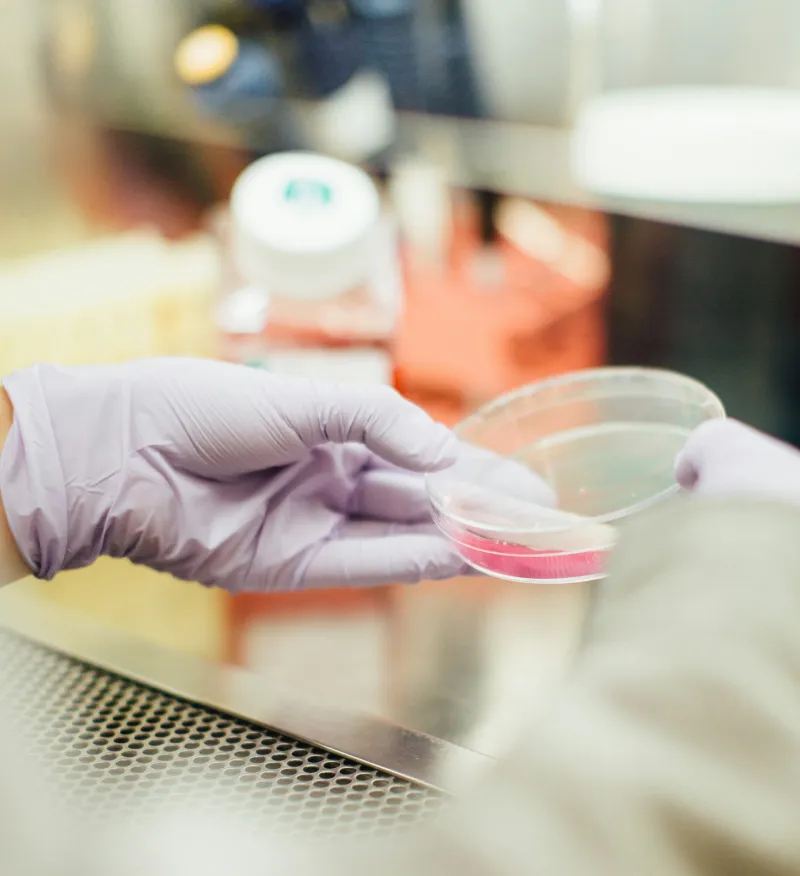

Helping a medical company achieve financial stability and growth
Ut porttitor nisl et massa fermentum cursus. Nam gravida facilisis nunc, in malesuada ex rutrum ut. Integer iaculis finibus diam, quis hendrerit mauris euismod eget. Proin nulla purus, pulvinar vitae dictum quis, interdum ut magna.